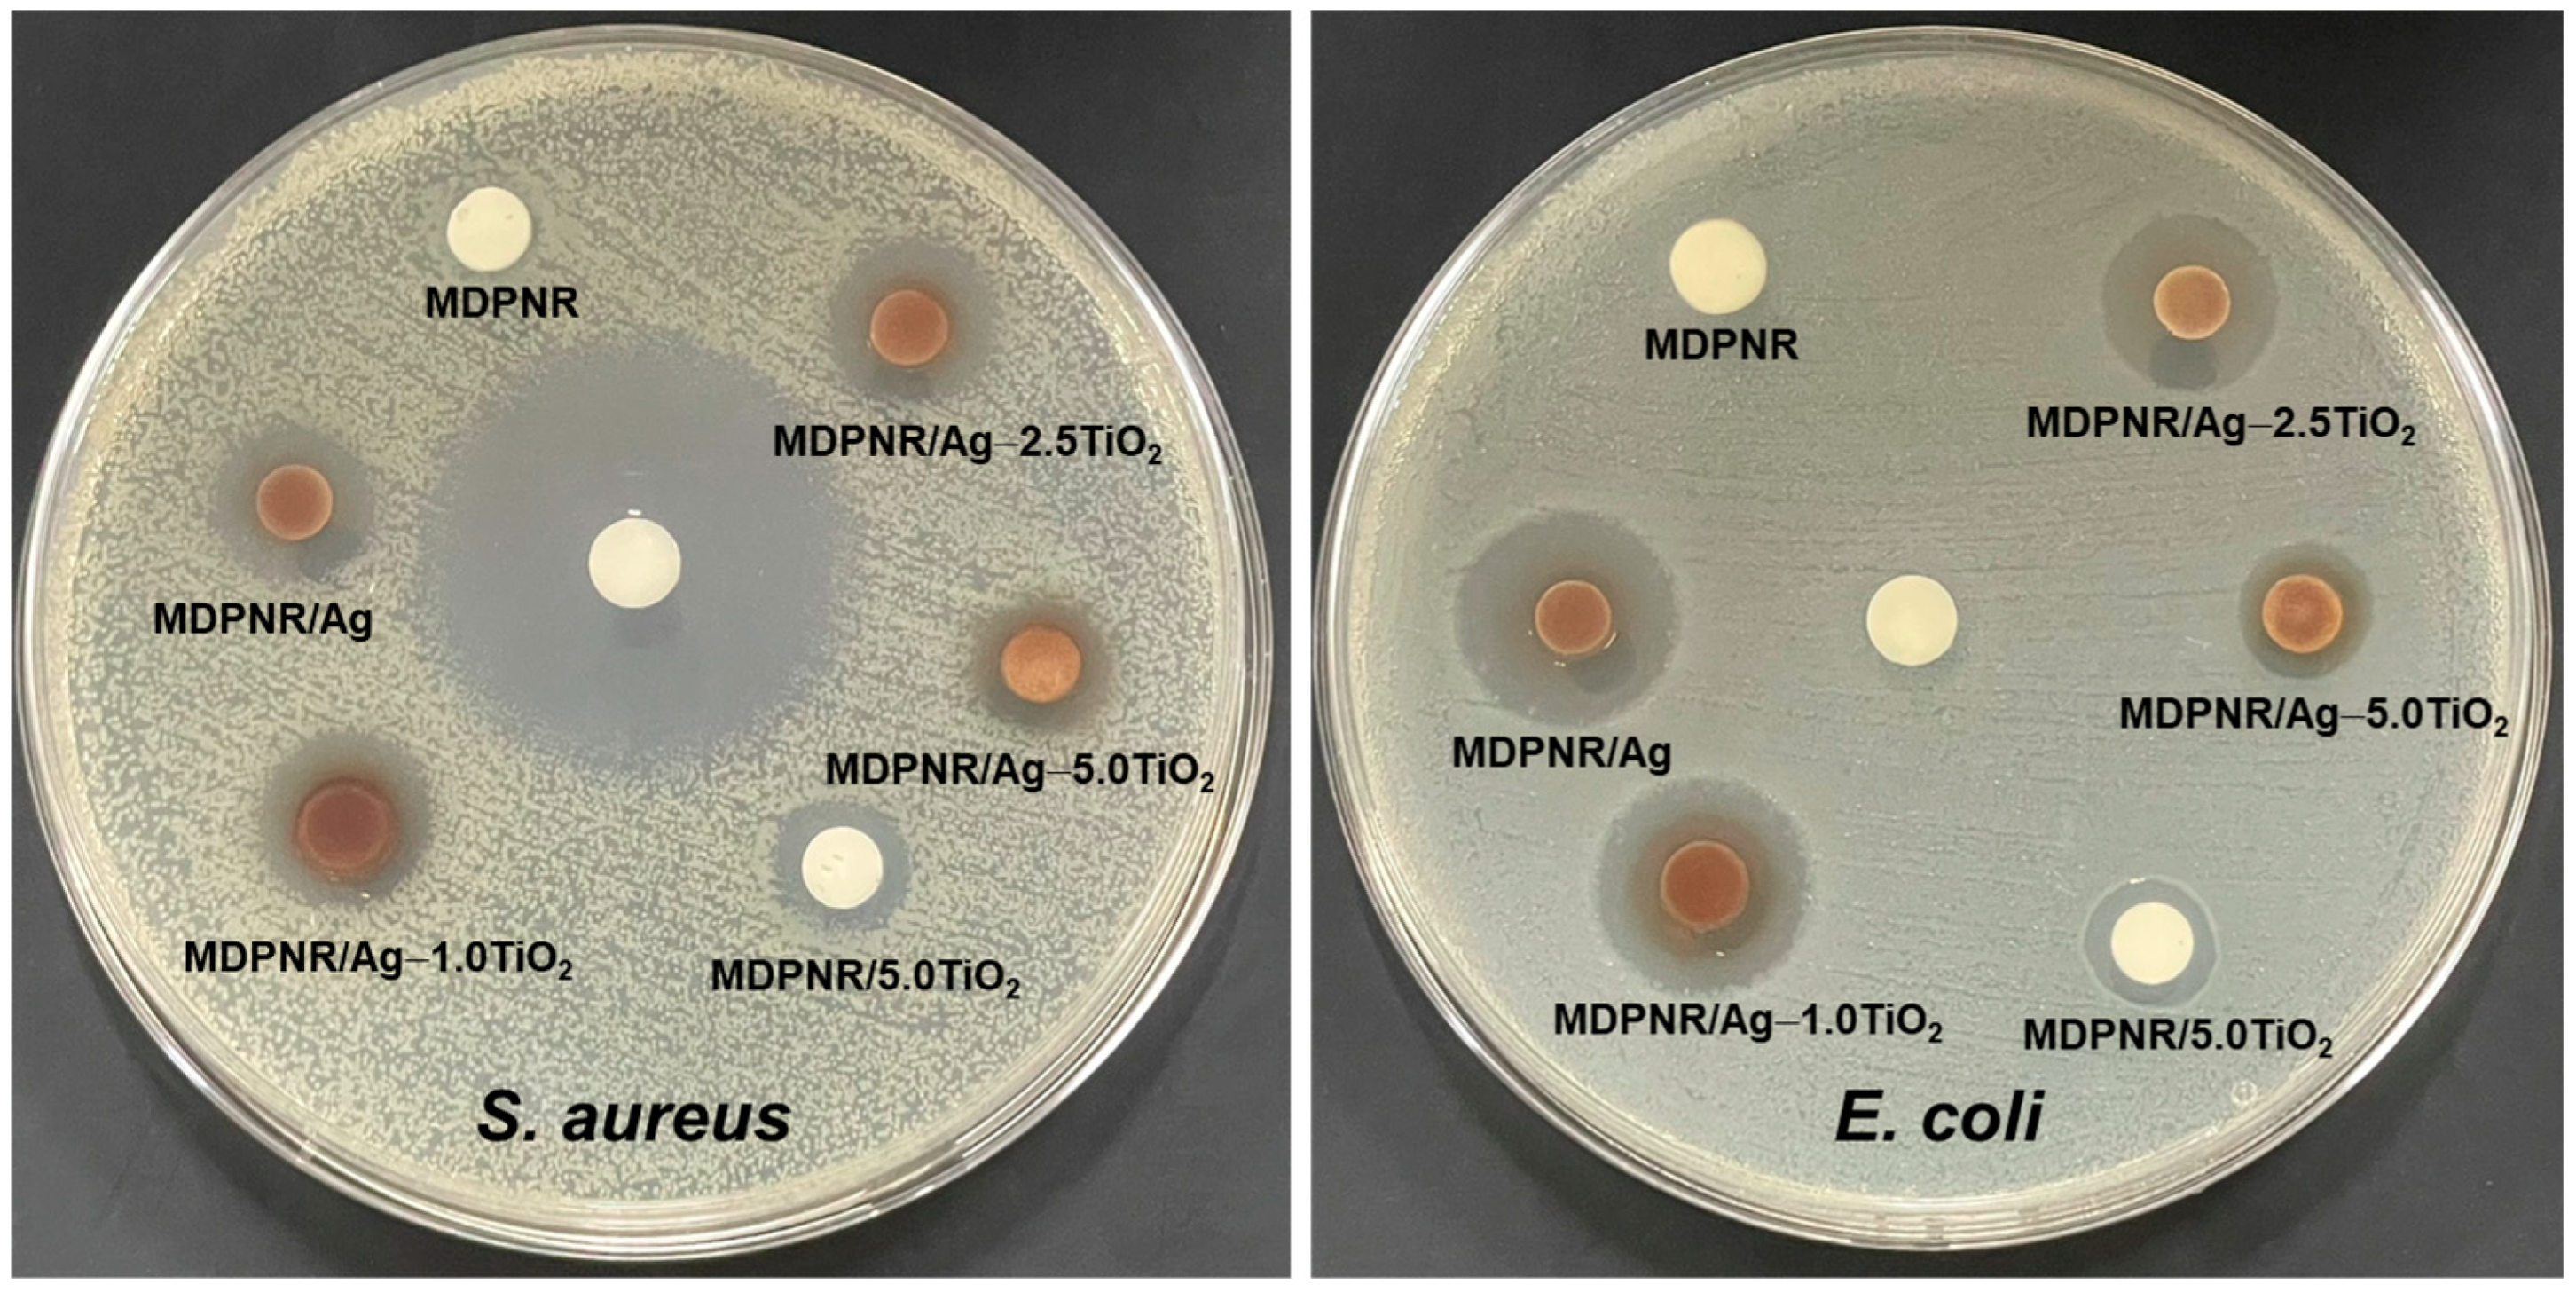
Polymers 16 03218 g008

Enhanced Dielectric Properties and Antibacterial Activity of Natural Rubber by Modification with Poly(Acrylic Acid-Co-Acrylamide) Incorporating Silver Nanoparticles and Titanium Dioxide
Abstract
1. Introduction
2. Materials and Methods
2.1. Materials
2.2. Preparation of Poly(Acrylic Acid-Co-Acrylamide)-Modified, Deproteinized Natural Rubber Comprising Silver Nanoparticles and Titanium Dioxide (MDPNR/Ag-TiO2) Composites
2.3. Fourier Transform Infrared Spectroscopy
2.4. Morphological Analysis
2.5. Thermogravimetric Analysis
2.6. Dynamic Mechanical Analysis
2.7. Dielectric Constant Testing
2.8. Antibacterial Activity Evaluation
3. Results
3.1. FTIR Analysis
3.2. Morphology
3.3. Thermal Properties
3.4. Dynamic Mechanical Properties
3.5. Dielectric Property
3.6. Antibacterial Activity
4. Conclusions
Author Contributions
Funding
Institutional Review Board Statement
Data Availability Statement
Acknowledgments
Conflicts of Interest
References
- Mahalingam, S.; Manap, A.; Lau, K.S.; Floresyona, D.; Medali Rachman, R.; Ayu Pradanawati, S.; Rabeya, R.; Chia, C.H.; Afandi, N.; Nugroho, A. Review of bioresource-based conductive composites for portable flexible electronic devices. Renew. Sustain. Energy Rev. 2024, 189, 113999. [Google Scholar] [CrossRef]
- Zhang, L.; Shan, X.; Bass, P.; Tong, Y.; Rolin, T.D.; Hill, C.W.; Brewer, J.C.; Tucker, D.S.; Cheng, Z.Y. Process and Microstructure to Achieve Ultra-high Dielectric Constant in Ceramic-Polymer Composites. Sci. Rep. 2016, 6, 35763. [Google Scholar] [CrossRef] [PubMed]
- Rubrice, K.; Castel, X.; Himdi, M.; Parneix, P. Dielectric Characteristics and Microwave Absorption of Graphene Composite Materials. Materials 2016, 9, 825. [Google Scholar] [CrossRef]
- Kumar, A.; Ahmad, D.; Patra, K.; Hossain, M. Enhancement of electromechanical properties of natural rubber by adding barium titanate filler: An electro-mechanical study. J. Appl. Polym. Sci. 2021, 138, 50991. [Google Scholar] [CrossRef]
- Kitisavetjit, W.; Nakaramontri, Y.; Pichaiyut, S.; Wisunthorn, S.; Kiatkamjornwong, S. Influences of carbon nanotubes and graphite hybrid filler on properties of natural rubber nanocomposites. Polym. Test. 2020, 93, 106981. [Google Scholar] [CrossRef]
- Rajapaksha, N.; Perera, K.; Vidanapathirana, K. Characterization of a natural rubber based solid polymer electrolyte to be used for a magnesium rechargeable cell. Polym. Bull. 2022, 79, 4879. [Google Scholar] [CrossRef]
- Yang, Y.; Zhao, G.; Cheng, X.; Deng, H.; Fu, Q. Stretchable and Healable Conductive Elastomer Based on PEDOT:PSS/Natural Rubber for Self-Powered Temperature and Strain Sensing. ACS Appl. Mater. Interfaces 2021, 13, 14599. [Google Scholar] [CrossRef]
- Sarih, N.M.; Gwee, K.; Maher, S.; Rashid, A.A. Natural Rubber (NR) Latex Films with Antimicrobial Properties for Stethoscope Diaphragm Covers. Materials 2022, 15, 3433. [Google Scholar] [CrossRef]
- Thomas, S.; Parameswaranpillai, J.; Krishnasamy, S.; Begam, P.M.; Nandi, D.; Siengchin, S.; George, J.; Hameed, N.; Salim, N.; Sienkiewicz, N. A comprehensive review on cellulose, chitin, and starch as fillers in natural rubber biocomposites. Carbohydr. Polym. Technol. Appl. 2021, 2, 100095. [Google Scholar] [CrossRef]
- Pan, H.; Wang, Z.; Cui, Y.; Cao, L.; Zong, C. Influences of porous reduction graphene oxide/molybdenum disulfide as filler on dielectric properties, thermal stability, and mechanical properties of natural rubber. J. Vinyl Addit. Technol. 2021, 27, 868. [Google Scholar] [CrossRef]
- Li, L.; Han, L.; Hu, H.; Zhang, R. A review on polymers and their composites for flexible electronics. Mater. Adv. 2023, 4, 726. [Google Scholar] [CrossRef]
- Ni, Y.; Yang, D.; Wei, Q.; Yu, L.; Ai, J.; Zhang, L. Plasticizer-induced enhanced electromechanical performance of natural rubber dielectric elastomer composites. Compos. Sci. Technol. 2020, 195, 108202. [Google Scholar] [CrossRef]
- Tian, M.; Zhang, J.; Zhang, L.; Liu, S.; Zan, X.; Nishi, T.; Ning, N. Graphene encapsulated rubber latex composites with high dielectric constant, low dielectric loss and low percolation threshold. J. Colloid Interface Sci. 2014, 430, 249. [Google Scholar] [CrossRef] [PubMed]
- Inphonlek, S.; Bureewong, N.; Jarukumjorn, K.; Chumsamrong, P.; Ruksakulpiwat, C.; Ruksakulpiwat, Y. Preparation of Poly(acrylic acid-co-acrylamide)-Grafted Deproteinized Natural Rubber and Its Effect on the Properties of Natural Rubber/Silica Composites. Polymers 2022, 14, 4602. [Google Scholar] [CrossRef]
- Pichayakorn, W.; Suksaeree, J.; Boonme, P.; Taweepreda, W.; Ritthidej, G.C. Preparation of Deproteinized Natural Rubber Latex and Properties of Films Formed by Itself and Several Adhesive Polymer Blends. Ind. Eng. Chem. Res. 2012, 51, 13393. [Google Scholar] [CrossRef]
- Inphonlek, S.; Ruksakulpiwat, C.; Ruksakulpiwat, Y. The Effect of Silver Nanoparticles/Titanium Dioxide in Poly(acrylic acid-co-acrylamide)-Modified, Deproteinized, Natural Rubber Composites on Dye Removal. Polymers 2023, 16, 92. [Google Scholar] [CrossRef]
- Niu, B.; Wang, X.; Wu, K.; He, X.; Zhang, R. Mesoporous Titanium Dioxide: Synthesis and Applications in Photocatalysis, Energy and Biology. Materials 2018, 11, 1910. [Google Scholar] [CrossRef]
- Toro, R.G.; Diab, M.; de Caro, T.; Al-Shemy, M.; Adel, A.; Caschera, D. Study of the Effect of Titanium Dioxide Hydrosol on the Photocatalytic and Mechanical Properties of Paper Sheets. Materials 2020, 13, 1326. [Google Scholar] [CrossRef]
- Bunriw, W.; Harnchana, V.; Chanthad, C.; Huynh, V.N. Natural Rubber-TiO2 Nanocomposite Film for Triboelectric Nanogenerator Application. Polymers 2021, 13, 2213. [Google Scholar] [CrossRef]
- Tan, X.; Liu, S.; Hu, X.; Zhang, R.; Su, X.; Qian, R.; Mai, Y.; Xu, Z.; Jing, W.; Tian, W.; et al. Near-Infrared-Enhanced Dual Enzyme-Mimicking Ag–TiO2–x@Alginate Microspheres with Antibactericidal and Oxygeneration Abilities to Treat Periodontitis. ACS Appl. Mater. Interfaces 2023, 15, 391. [Google Scholar] [CrossRef]
- Liao, C.; Li, Y.; Tjong, S.C. Visible-Light Active Titanium Dioxide Nanomaterials with Bactericidal Properties. Nanomaterials 2020, 10, 124. [Google Scholar] [CrossRef] [PubMed]
- Zhang, Y.; Li, Q.; Gao, Q.; Wan, S.; Yao, P.; Zhu, X. Preparation of Ag/β-cyclodextrin co-doped TiO2 floating photocatalytic membrane for dynamic adsorption and photoactivity under visible light. Appl. Catal. B Environ. 2020, 267, 118715. [Google Scholar] [CrossRef]
- Ponja, S.D.; Sehmi, S.K.; Allan, E.; MacRobert, A.J.; Parkin, I.P.; Carmalt, C.J. Enhanced Bactericidal Activity of Silver Thin Films Deposited via Aerosol-Assisted Chemical Vapor Deposition. ACS Appl. Mater. Interfaces 2015, 7, 28616. [Google Scholar] [CrossRef] [PubMed]
- Appamato, I.; Bunriw, W.; Harnchana, V.; Siriwong, C.; Mongkolthanaruk, W.; Thongbai, P.; Chanthad, C.; Chompoosor, A.; Ruangchai, S.; Prada, T.; et al. Engineering Triboelectric Charge in Natural Rubber–Ag Nanocomposite for Enhancing Electrical Output of a Triboelectric Nanogenerator. ACS Appl. Mater. Interfaces 2023, 15, 973. [Google Scholar] [CrossRef]
- Soo, J.Z.; Chai, L.C.; Ang, B.C.; Ong, B.H. Enhancing the Antibacterial Performance of Titanium Dioxide Nanofibers by Coating with Silver Nanoparticles. ACS Appl. Nano Mater. 2020, 3, 5743. [Google Scholar] [CrossRef]
- Kawahara, S.; Klinklai, W.; Kuroda, H.; Isono, Y. Removal of proteins from natural rubber with urea. Polym. Adv. Technol. 2004, 15, 181. [Google Scholar] [CrossRef]
- Algethami, N.; Rajeh, A.; Ragab, H.; Tarabiah, A.; Gami, F. Characterization, optical, and electrical properties of chitosan/polyacrylamide blend doped silver nanoparticles. J. Mater. Sci. Mater. Electron. 2022, 33, 10645. [Google Scholar] [CrossRef]
- Mkrtchyan, K.V.; Pigareva, V.A.; Zezina, E.A.; Kuznetsova, O.A.; Semenova, A.A.; Yushina, Y.K.; Tolordava, E.R.; Grudistova, M.A.; Sybachin, A.V.; Klimov, D.I.; et al. Preparation of Biocidal Nanocomposites in X-ray Irradiated Interpolyelectolyte Complexes of Polyacrylic Acid and Polyethylenimine with Ag-Ions. Polymers 2022, 14, 4417. [Google Scholar] [CrossRef] [PubMed]
- Kanehira, K.; Banzai, T.; Ogino, C.; Shimizu, N.; Kubota, Y.; Sonezaki, S. Properties of TiO2–polyacrylic acid dispersions with potential for molecular recognition. Colloids Surf. B Biointerfaces 2008, 64, 10. [Google Scholar] [CrossRef]
- Joy, J.; Abraham, J.; Rajeevan, S.; George, S. Synthesis and characterization of natural rubber/graphene quantum dot nanocomposites. J. Polym. Res. 2021, 28, 358. [Google Scholar]
- Mendoza, D.J.; Ayurini, M.; Raghuwanshi, V.S.; Simon, G.P.; Hooper, J.F.; Garnier, G. Synthesis of Superabsorbent Polyacrylic Acid-Grafted Cellulose Nanofibers via Silver-Promoted Decarboxylative Radical Polymerization. Macromolecules 2023, 56, 3497. [Google Scholar] [CrossRef]
- Liu, Z.-K.; Deng, S.-S.; Zhou, Y.; Tong, Z.; Liu, J.-K.; Wang, Z.; Guo, M.-J.; Deng, L.; Zhen, Y.; Li, J.-T.; et al. On-Site Cross-Linking of Polyacrylamide to Efficiently Bind the Silicon Anode of Lithium-Ion Batteries. ACS Appl. Mater. Interfaces 2023, 15, 24416. [Google Scholar] [CrossRef] [PubMed]
- Anancharoenwong, E.; Chueangchayaphan, W.; Rakkapao, N.; Marthosa, S.; Chaisrikhwun, B. Thermo-mechanical and antimicrobial properties of natural rubber-based polyurethane nanocomposites for biomedical applications. Polym. Bull. 2021, 78, 833. [Google Scholar] [CrossRef]
- Yu, S.; Li, N.; Higgins, D.; Li, D.; Li, Q.; Xu, H.; Spendelow, J.S.; Wu, G. Self-Assembled Reduced Graphene Oxide/Polyacrylamide Conductive Composite Films. ACS Appl. Mater. Interfaces 2014, 6, 19783. [Google Scholar] [CrossRef] [PubMed]
- Demchenko, V.; Rybalchenko, N.; Zahorodnia, S.; Naumenko, K.; Riabov, S.; Kobylinskyi, S.; Vashchuk, A.; Mamunya, Y.; Iurzhenko, M.; Demchenko, O.; et al. Preparation, Characterization, and Antimicrobial and Antiviral Properties of Silver-Containing Nanocomposites Based on Polylactic Acid–Chitosan. ACS Appl. Bio Mater. 2022, 5, 2576. [Google Scholar] [CrossRef]
- Pai, K.R.N.; Anjusree, G.S.; Deepak, T.G.; Subash, D.; Nair, S.V.; Nair, A.S. High surface area TiO2 nanoparticles by a freeze-drying approach for dye-sensitized solar cells. RSC Adv. 2014, 4, 36821. [Google Scholar] [CrossRef]
- Bhardwaj, D.; Singh, R. Green biomimetic synthesis of Ag–TiO2 nanocomposite using Origanum majorana leaf extract under sonication and their biological activities. Bioresour. Bioprocess. 2021, 8, 1. [Google Scholar] [CrossRef]
- Vyatskikh, A.; Ng, R.C.; Edwards, B.; Briggs, R.M.; Greer, J.R. Additive Manufacturing of High-Refractive-Index, Nanoarchitected Titanium Dioxide for 3D Dielectric Photonic Crystals. Nano Lett. 2020, 20, 3513. [Google Scholar] [CrossRef]
- Eddy, D.R.; Ishmah, S.N.; Permana, M.D.; Firdaus, M.L. Synthesis of Titanium Dioxide/Silicon Dioxide from Beach Sand as Photocatalyst for Cr and Pb Remediation. Catalysts 2020, 10, 1248. [Google Scholar] [CrossRef]
- Beyler-Çiǧil, A.; Şen, F.; Birtane, H.; Kahraman, M. Covalently bonded nanosilver-hydroxyethyl cellulose/polyacrylic acid/sorbitol hybrid matrix: Thermal, morphological and antibacterial properties. Polym. Bull. 2022, 79, 11353. [Google Scholar] [CrossRef]
- Liu, Y.; Yan, Y.; Zhao, L.; Zhang, Y.; Zhang, L.; Zan, X. Thermally stable poly (acrylic acid-acrylamide-biomass-fly ash) composites with improved temperature resistance and salt resistance. J. Appl. Polym. Sci. 2022, 139, 51533. [Google Scholar] [CrossRef]
- Noipitak, P.; Inphonlek, S.; Nillawong, M.; Sunintaboon, P.; Amornsakchai, T. Chitosan/alginate composite porous hydrogels reinforced with PHEMA/PEI core–shell particles and pineapple-leaf cellulose fibers: Their physico-mechanical properties and ability to incorporate AgNP. J. Polym. Res. 2021, 28, 182. [Google Scholar] [CrossRef]
- Bashir, M.A. Use of Dynamic Mechanical Analysis (DMA) for Characterizing Interfacial Interactions in Filled Polymers. Solids 2021, 2, 108–120. [Google Scholar] [CrossRef]
- Ren, X.; Barrera, C.S.; Tardiff, J.L.; Cornish, K. Sustainable Epoxidized Guayule Natural Rubber, Blends and Composites with Improved Oil Resistance and Greater Stiffness. Materials 2022, 15, 3946. [Google Scholar] [CrossRef] [PubMed]
- Fahmy, A.; Agudo Jácome, L.; Schönhals, A. Effect of Silver Nanoparticles on the Dielectric Properties and the Homogeneity of Plasma Poly(acrylic acid) Thin Films. J. Phys. Chem. C 2020, 124, 22817. [Google Scholar] [CrossRef]
- Liufu, S.; Xiao, H.; Li, Y. Adsorption of poly(acrylic acid) onto the surface of titanium dioxide and the colloidal stability of aqueous suspension. J. Colloid Interface Sci. 2005, 281, 155. [Google Scholar] [CrossRef]
- Abdali, K.; Al-Bermany, E.; Haneen, K. Impact the silver nanoparticles on properties of new fabricated polyvinyl alcohol-polyacrylamide-polyacrylic acid nanocomposites films for optoelectronics and radiation pollution applications. J. Polym. Res. 2023, 30, 138. [Google Scholar] [CrossRef]
- Mrudula, M.; Nair, M. Dielectric properties of natural rubber/polyethylene oxide block copolymer complexed with transition metal ions. Polym. Bull. 2020, 77, 6029. [Google Scholar] [CrossRef]
- Liu, X.; Sun, H.; Liu, S.; Jiang, Y.; Yin, Z.; Yu, B.; Ning, N.; Tian, M.; Zhang, L. Dielectric elastomer sensor with high dielectric constant and capacitive strain sensing properties by designing polar-nonpolar fluorosilicone multiblock copolymers and introducing poly(dopamine) modified CNTs. Compos. Part B Eng. 2021, 223, 109103. [Google Scholar] [CrossRef]
- Wang, Q.; Liu, X.; Qiang, Z.; Hu, Z.; Cui, X.; Wei, H.; Hu, J.; Xia, Y.; Huang, S.; Zhang, J.; et al. Cellulose nanocrystal enhanced, high dielectric 3D printing composite resin for energy applications. Compos. Sci. Technol. 2022, 227, 109601. [Google Scholar] [CrossRef]
- Petchnui, K.; Uwanno, T.; Phonyiem Reilly, M.; Pinming, C.; Treetong, A.; Yordsri, V.; Moolsradoo, N.; Klamcheun, A.; Wongwiriyapan, W. Preparation of Chitin Nanofibers and Natural Rubber Composites and Their Triboelectric Nanogenerator Applications. Materials 2024, 17, 738. [Google Scholar] [CrossRef] [PubMed]
- Suphasorn, P.; Appamato, I.; Harnchana, V.; Thongbai, P.; Chanthad, C.; Siriwong, C.; Amornkitbamrung, V. Ag Nanoparticle-Incorporated Natural Rubber for Mechanical Energy Harvesting Application. Molecules 2021, 26, 2720. [Google Scholar] [CrossRef] [PubMed]
- Sreenivasan, D.P.; Sujith, A.; Asokan, A.N.; Rajesh, C. Dielectric Properties of Composites of Natural Rubber and Keratin Fibre from Chicken Feather. Fibers Polym. 2021, 22, 2588. [Google Scholar] [CrossRef]
- Sintharm, P.; Phisalaphong, M. Green Natural Rubber Composites Reinforced with Black/White Rice Husk Ashes: Effects of Reinforcing Agent on Film’s Mechanical and Dielectric Properties. Polymers 2021, 13, 882. [Google Scholar] [CrossRef]
- Demchenko, V.; Mamunya, Y.; Kobylinskyi, S.; Riabov, S.; Naumenko, K.; Zahorodnia, S.; Povnitsa, O.; Rybalchenko, N.; Iurzhenko, M.; Adamus, G.; et al. Structure-Morphology-Antimicrobial and Antiviral Activity Relationship in Silver-Containing Nanocomposites Based on Polylactide. Molecules 2022, 27, 3769. [Google Scholar] [CrossRef]

| Samples | Weight (%) | Atomic (%) | ||||||||
|---|---|---|---|---|---|---|---|---|---|---|
| C | O | Na | Ag | Ti | C | O | Na | Ag | Ti | |
| MDPNR | 84.67 | 14.57 | 0.76 | 0.00 | 0.00 | 88.19 | 11.39 | 0.41 | 0.00 | 0.00 |
| MDPNR/Ag | 75.88 | 19.40 | 3.65 | 1.08 | 0.00 | 82.06 | 15.75 | 2.06 | 0.13 | 0.00 |
| MDPNR/Ag-1.0TiO2 | 75.63 | 19.65 | 2.23 | 0.96 | 1.53 | 82.17 | 16.03 | 1.26 | 0.12 | 0.42 |
| MDPNR/Ag-2.5TiO2 | 70.93 | 19.92 | 1.72 | 0.75 | 6.69 | 80.11 | 16.89 | 1.01 | 0.09 | 1.90 |
| MDPNR/Ag-5.0TiO2 | 69.26 | 19.69 | 2.22 | 0.61 | 8.21 | 79.31 | 16.93 | 1.33 | 0.08 | 2.36 |
| MDPNR/5.0TiO2 | 66.44 | 25.73 | 2.93 | 0.00 | 4.90 | 75.06 | 21.82 | 1.73 | 0.00 | 1.39 |
| Samples | T5 (°C) | Tmax (°C) | Residue at 600 °C (%) |
|---|---|---|---|
| DPNR | 343.61 | 376.61 | 0.36 |
| MDPNR | 307.69 | 381.69 | 8.38 |
| MDPNR/Ag | 306.44 | 380.96 | 10.01 |
| MDPNR/Ag-1.0TiO2 | 302.27 | 383.27 | 10.28 |
| MDPNR/Ag-2.5TiO2 | 279.08 | 381.08 | 11.02 |
| MDPNR/Ag-5.0TiO2 | 291.98 | 380.98 | 14.57 |
| MDPNR/5.0TiO2 | 301.16 | 380.16 | 12.62 |
| Samples | Tan δ Peak Position (°C) | Tan δ Peak Height |
|---|---|---|
| DPNR | −54.89 | 2.861 |
| MDPNR | −57.21 | 1.045 |
| MDPNR/Ag | −57.28 | 0.858 |
| MDPNR/Ag-1.0TiO2 | −56.90 | 0.933 |
| MDPNR/Ag-2.5TiO2 | −56.41 | 0.939 |
| MDPNR/Ag-5.0TiO2 | −55.43 | 0.908 |
| MDPNR/5.0TiO2 | −56.83 | 1.036 |
| Samples | Zone of Inhibition (mm) | |
|---|---|---|
| S. aureus | E. coli | |
| MDPNR | 0.0 ± 0.0 | 0.0 ± 0.0 |
| MDPNR/Ag | 12.0 ± 1.0 | 15.3 ± 0.6 |
| MDPNR/Ag-1.0TiO2 | 11.7 ± 0.6 | 14.0 ± 0.0 |
| MDPNR/Ag-2.5TiO2 | 12.0 ± 0.0 | 13.7 ± 0.6 |
| MDPNR/Ag-5.0TiO2 | 10.7 ± 1.5 | 11.3 ± 2.5 |
| MDPNR/5.0TiO2 | 9.3 ± 1.2 | 8.7 ± 0.6 |
Disclaimer/Publisher’s Note: The statements, opinions and data contained in all publications are solely those of the individual author(s) and contributor(s) and not of MDPI and/or the editor(s). MDPI and/or the editor(s) disclaim responsibility for any injury to people or property resulting from any ideas, methods, instructions or products referred to in the content. |
© 2024 by the authors. Licensee MDPI, Basel, Switzerland. This article is an open access article distributed under the terms and conditions of the Creative Commons Attribution (CC BY) license (https://creativecommons.org/licenses/by/4.0/).
Share and Cite
Inphonlek, S.; Kotchapradit, S.; Marungsri, B.; Ruksakulpiwat, Y.; Ruksakulpiwat, C. Enhanced Dielectric Properties and Antibacterial Activity of Natural Rubber by Modification with Poly(Acrylic Acid-Co-Acrylamide) Incorporating Silver Nanoparticles and Titanium Dioxide. Polymers 2024, 16, 3218. https://doi.org/10.3390/polym16223218
Inphonlek S, Kotchapradit S, Marungsri B, Ruksakulpiwat Y, Ruksakulpiwat C. Enhanced Dielectric Properties and Antibacterial Activity of Natural Rubber by Modification with Poly(Acrylic Acid-Co-Acrylamide) Incorporating Silver Nanoparticles and Titanium Dioxide. Polymers. 2024; 16(22):3218. https://doi.org/10.3390/polym16223218
Chicago/Turabian StyleInphonlek, Supharat, Supawat Kotchapradit, Boonruang Marungsri, Yupaporn Ruksakulpiwat, and Chaiwat Ruksakulpiwat. 2024. "Enhanced Dielectric Properties and Antibacterial Activity of Natural Rubber by Modification with Poly(Acrylic Acid-Co-Acrylamide) Incorporating Silver Nanoparticles and Titanium Dioxide" Polymers 16, no. 22: 3218. https://doi.org/10.3390/polym16223218
APA StyleInphonlek, S., Kotchapradit, S., Marungsri, B., Ruksakulpiwat, Y., & Ruksakulpiwat, C. (2024). Enhanced Dielectric Properties and Antibacterial Activity of Natural Rubber by Modification with Poly(Acrylic Acid-Co-Acrylamide) Incorporating Silver Nanoparticles and Titanium Dioxide. Polymers, 16(22), 3218. https://doi.org/10.3390/polym16223218

